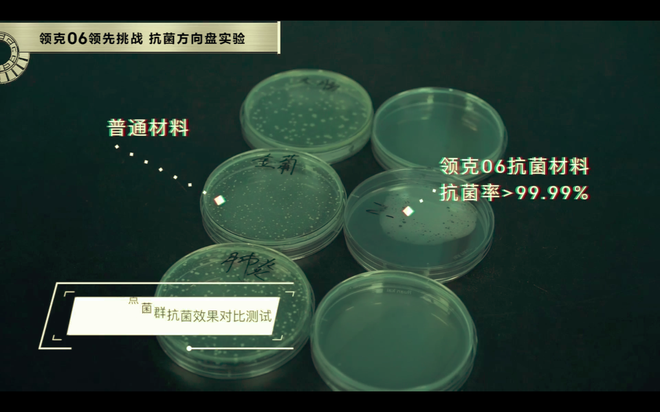
安全性比肩沃尔沃 揭秘领克06三大安全护身符

个人信息不会泄露给第三方

2020年7月5日,领克06 (配置|询价)成功完成三大安全黑科技的首次挑战。通过联合中国汽车技术研究中心、广东省微生物研究所,对“翻滚保护系统、五重空气净化、抗菌方向盘”逐一测试。行车安全、车内安全都不容忽视,一场不同以往的测试,让我们来揭秘领克06三大安全护身符。

作为首款搭载RP(Rollover Protection)翻滚保护系统的车型,领克06在翻滚方面配备了“防护安全双保险”。搭载博世9.3ESP车辆稳定控制系统,本身对侧翻有主动预防措施,不容易发生侧翻。


更重要的是,在不可避免的翻滚场景下,车辆搭载的翻滚保护系统被动部分防护能够及时启动,在危难时刻,保护司乘人员的安全。该保护系统也是针对国内道路及路况开发设计,也是国内第一款翻滚保护系统,也是中国品牌首次量产搭载。


在实验中,领克06的试验车,以较高的速度行驶,通过单边桥后发生螺旋状侧翻。在车辆感应到即将发生翻滚的瞬间,气囊提前打开,对于车内假人有着很好的保护,34L超大侧气帘带有6秒保压时间。即使连续翻滚,也可以最大限度保护前后排乘客。



此外,根据中国道路交通事故调研,基于大数据进行13项翻滚路况模拟测试。同时,通过多次模拟与全车承载成年男性/成年女性、无儿童座椅保护未成年人伤害考察和气囊参数匹配。从2016年开始,历经40多次的实车翻滚测试,模拟测试时间累计超过15000小时。翻滚保护系统进行了螺旋翻滚、边坡翻滚、沙坑侧翻、路阶侧翻4大类型翻滚工况模拟。

车辆在发生翻滚的同时,车辆已经自启动紧急呼叫救援功能,屏幕上显示SOS。领克06会自动收集车况信息(碰撞速度、行驶方向等)和定位信息(GPS坐标),并在第一时间将以上信息发送至后台,后台会第一时间与客户建立语音通话。

领克06不但有很好的翻滚保护系统、延时气囊这样的柔性保护。它也有一身钢筋铁骨,首创双侧双吸能盒设计,增大碰撞吸能面积,有效增加碰撞吸收能力,减少碰撞事故中冲击造成的伤害。


独创11项车身专利设计,以创新实现安全再进化。不仅强化了一身铮铮铁骨,更好的梳理冲击的力量。通过缓冲和形变,更好的保护乘员舱。

在吸能盒后部通过第一个“人”字结构进行能量的初次分配,在前机舱纵梁根部通过“人”字结构进行能量的二次分配,减小对乘员舱的冲击。长吸能盒结构及纵梁折弯变形设计,使得在正面碰撞中吸能盒充分压溃、纵梁折弯变形以吸收更多的能量,保证乘员舱的完整性。


领克06座舱集合一键远程车窗透气、主动式座舱清洁系统、AQS空气质量管理系统、PM2.5/CN95级滤芯、负离子发生器。成为一个空气净化生态链闭环,这个生态链不仅会优势互补,更会功能联动、效力协同,为车主提供系统级的空气净化安全。


当车内空气质量较差时,车机会自动提醒驾驶员,同时自动开启清洁净化功能。短短几分钟内就可以充分净化车内空气,这让很多喜欢车内抽烟的人来说,是个好帮手。同时,当你不在车内,也可以提前净化,让你上车时,车内保持良好的空气质量。

除了车内空气质量受到大家重视,方向盘作为我们手部接触最多的区域,它上面是否存在细菌,也影响着驾驶员和家人的健康。根据统计,驾驶员每天都要接触的方向盘上每平方厘米细菌含量最高可达800种。
方向盘采用无机抗菌剂(纳米银),兼具有机系的即效性、持续性与无机系的安全性、耐热性,对大肠杆菌、金黄色葡萄球菌、霉菌等生活中常见的细菌均有抑制作用。通过对细菌表面的蛋白质进行变性破坏,阻止其嵌入人体细胞,从而达到抗菌作用。具有高效的抑制、杀菌、防霉功能,实现方向盘自清洁,抗菌率高达99.9%。
领克06不仅延续家族优良的颜值和智能车机,在安全性上更是下了很大功夫,无论是钢筋铁骨应对翻滚,还是全面的净化应对车内的健康问题,它都拿出很有效的办法。领克在行车安全方面媲美沃尔沃,更是在车内健康上找到新的可能。内外诚意满满的新车为后浪而来,三大安全护身符保护你和家人的安全。